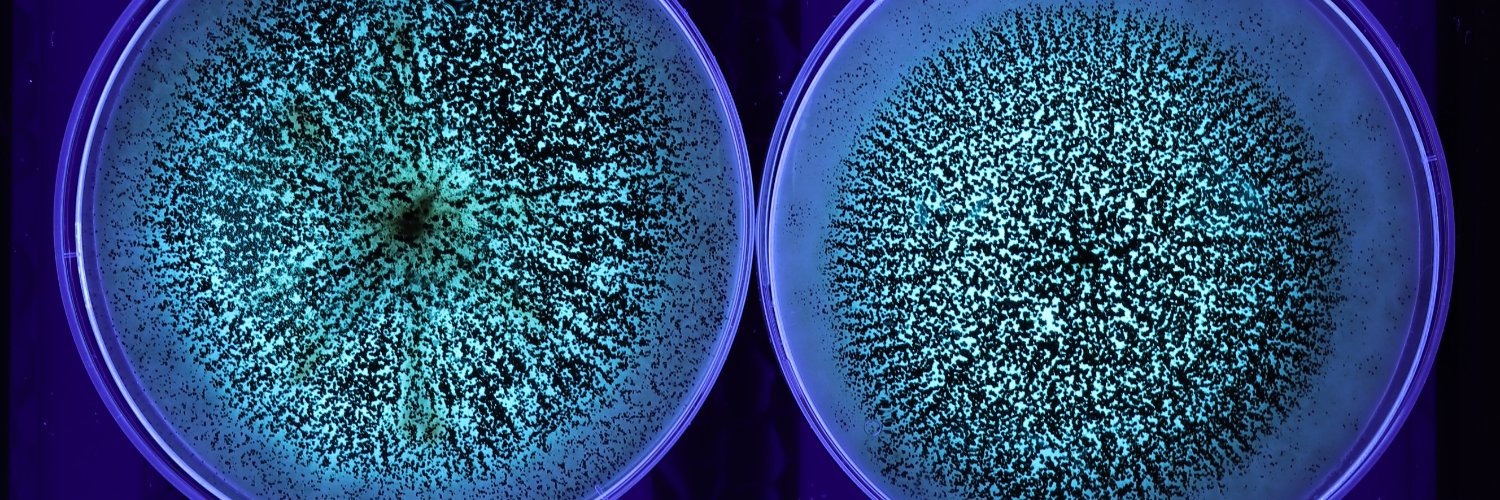
Claudia López Rodríguez 🇪🇸 banner

Claudia López Rodríguez 🇪🇸
249 posts

Claudia López Rodríguez 🇪🇸
@Lopez_science
Research Fellow in @deusto | PhD in Microbiology and Biotechnology between @qualisud and @CranMycology | Climate change & Health | 🎹🥊♀️











Check out our🆕 review paper by @Lopez_science on the reduction of #ochratoxin A in #coffee. Read the full paper here: JoF | Free Full-Text | Reduction in Ochratoxin A Occurrence in Coffee: From Good Practices to Biocontrol Agents (mdpi.com) @CaVaessenVe @qualisud

This week we celebrated @Lopez_science graduation, congratulations to Dr Claudia Lopez! We wish you all the best in your new role as a Post-doctoral researcher in Bilbao!




Our past undergraduate students have explored global change impacts on grasslands, forests and crops.But,which are the most used words in their final projects? Here are the top 5! 🥇Climate change🌍🔥 🥈Drought stress🏜️ 🥉Alternative crops🌱 4️⃣Agroecosystems🚜 5️⃣Plant response🌿

Only 2⃣ weeks until the 🍏#SRUKEvent of the YEAR!🎊 Do not miss the opportunity and come along to the 🫂#XISRUKSymposium in the 🌉toon to meet this amazing lineup of speakers! All ℹ️, 🎟️and more: symposium.sruk.org.uk/event-2024/



🙌¡Comienza la X Jornada sobre Vigilancia en Salud Pública de @seepidemiologia! #JornadaVigilanciaSEE24 @SaludISCIII @ozurri @pgullon #MarinaPollán @DadaCero Recuerda que puedes seguirla en directo a través de nuestro canal de Youtube📲youtube.com/watch?v=VnMlPM…






